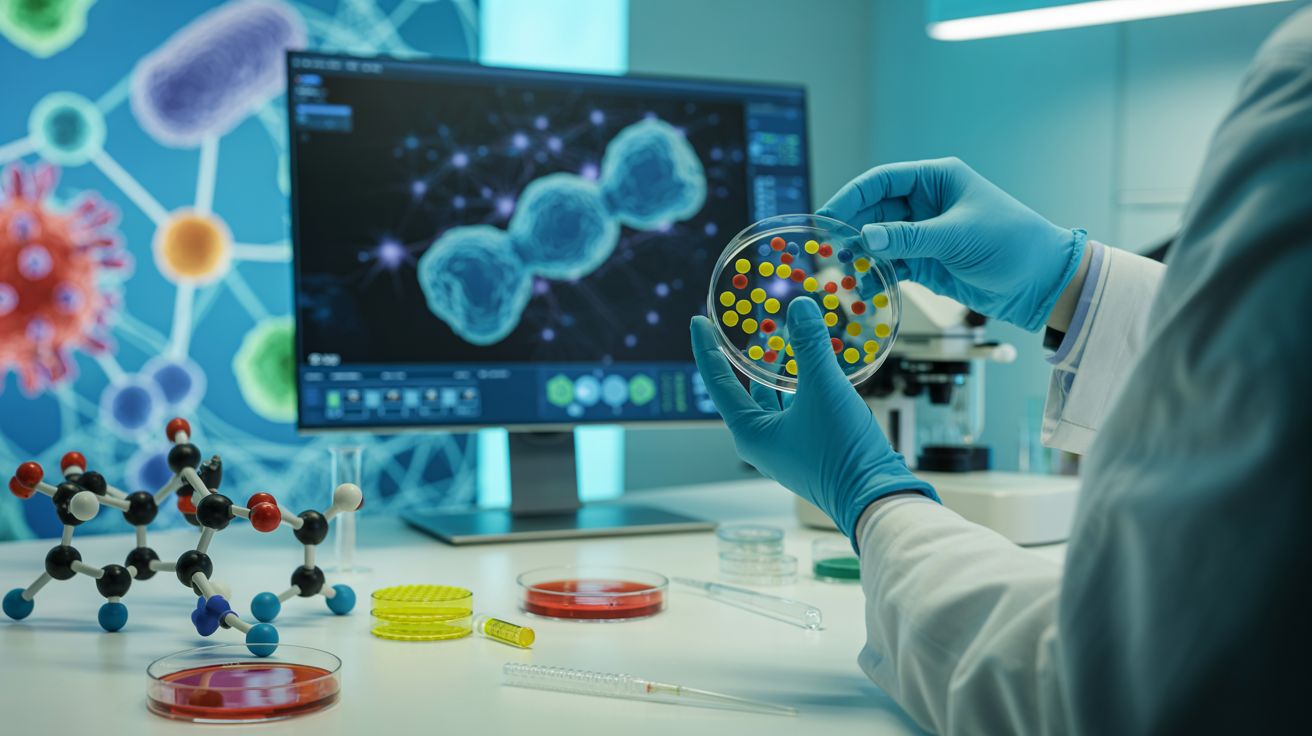

Onderzoekers van het Massachusetts Institute of Technology (MIT) hebben met behulp van generatieve kunstmatige intelligentie (AI) meer dan 36 miljoen moleculaire structuren gegenereerd en gescreend op antimicrobiële eigenschappen. Daaruit selecteerden ze twee baanbrekende verbindingen — NG1 en DN1 — die effectief bleken tegen geneesmiddel-resistente gonorroe en MRSA (methicilline-resistente Staphylococcus aureus).
Deze verbindingen bleken niet alleen effectief in celkweken, maar ook in muismodellen: NG1 wist resistente gonorroe te elimineren, terwijl DN1 een MRSA-huidinfectie succesvol boven de doopvont tilde. Bijzonder is hun mechanisme: ze werken via disruptie van de bacteriële celmembraan, een aanpak die afwijkt van traditionele antibiotica en mogelijk minder gevoelig is voor resistentieontwikkeling.
Hoewel dit een potentiële start van een “tweede gouden tijdperk” in antibiotica-ontwikkeling lijkt, benadrukken wetenschappers dat verder onderzoek en klinische proeven noodzakelijk zijn voordat menselijk gebruik mogelijk is.
|
AI designs new superbug-killing antibiotics for gonorrhoea and MRSATwo new potential drugs have been designed by AI to kill drug-resistant bacteria, in a major Massachusetts Institute of Technology study. |
Oeroud leven herbergt antibiotische goudmijnen: De archaeasins
Een team onder leiding van Marcelo D. T. Torres, Fangping Wan en César de la Fuente‑Núñez publiceerde op 12 augustus 2025 in Nature Microbiology hun ontdekking van antibiotische kandidaten in het proteoom van archaea — oeroude micro-organismen die zich op extreme locaties ontwikkelden.
Door deep learning toe te passen op het proteoom van 233 archaeale soorten, identificeerden ze duizenden potentiële antimicrobiële peptiden, die zij ‘archaeasins’ noemden. Van de 80 gesynthetiseerde archaeasins toonde maar liefst 93 % activiteit tegen resistente bacteriestammen zoals Acinetobacter baumannii, E. coli, Klebsiella pneumoniae, Pseudomonas aeruginosa en Staphylococcus aureus.
In muismodellen onderbraken deze verbindingen binnen vier dagen de verspreiding van resistente infecties; één synthetisch peptide bleek zelfs vergelijkbaar effectief met polymyxine B, een van de laatste verdedigingslinies tegen multi-resistente micro-organismen.
AI used to design antibiotics that can combat drug-resistant superbugs gonorrhoea and MRSAAntibiotics are used to kill bacteria, but some infections have become resistant to drugs. It is estimated drug-resistant bacterial infections cause nearly five million deaths per year worldwide. |
Een veelbelovende samensmelting
In beide cases — de AI-ontworpen NG1/DN1 en de natuurgeleide archaeasins — staat één thema centraal: AI maakt nieuwe chemische ruimtes toegankelijk, of ze nu ontstaan in computers of in microben van miljarden jaren oud. Deze benaderingen vullen elkaar aan: de AI-systemen ontwerpen moleculen die mensen nog nooit gemaakt hebben, terwijl de archaeale peptiden inspelen op evolutiegeschiedenis uit extreme omgevingen.
Using generative AI, researchers design compounds that can kill drug-resistant bacteriaWith help from artificial intelligence, MIT researchers designed novel antibiotics that can combat a drug-resistant form of Neisseria gonorrhoeae and multi-drug-resistant Staphylococcus aureus (MRSA). |
Het gezamenlijke potentieel vertegenwoordigt een zeldzame optimistische noot in de strijd tegen antimicrobiële resistentie, die jaarlijks miljoenen levens wereldwijd eist. Maar zoals onderzoekers herhaaldelijk benadrukken: deze doorbraken moeten nog gehard worden door laboratoriumvalidatie, veiligheidstests én klinische proeven.
De ontdekking van NG1, DN1 en de archaeasins opent nieuwe wegen in de zoektocht naar effectieve antibiotica. Het onderstreept dat technologie en natuurpartnerschap krachtige bondgenoten zijn in de geneeskunde van de toekomst. Journalisten, beleidsmakers en het grote publiek mogen hopen – maar ook waakzaam blijven voor de lange weg naar veilige, toegankelijke geneesmiddelen.